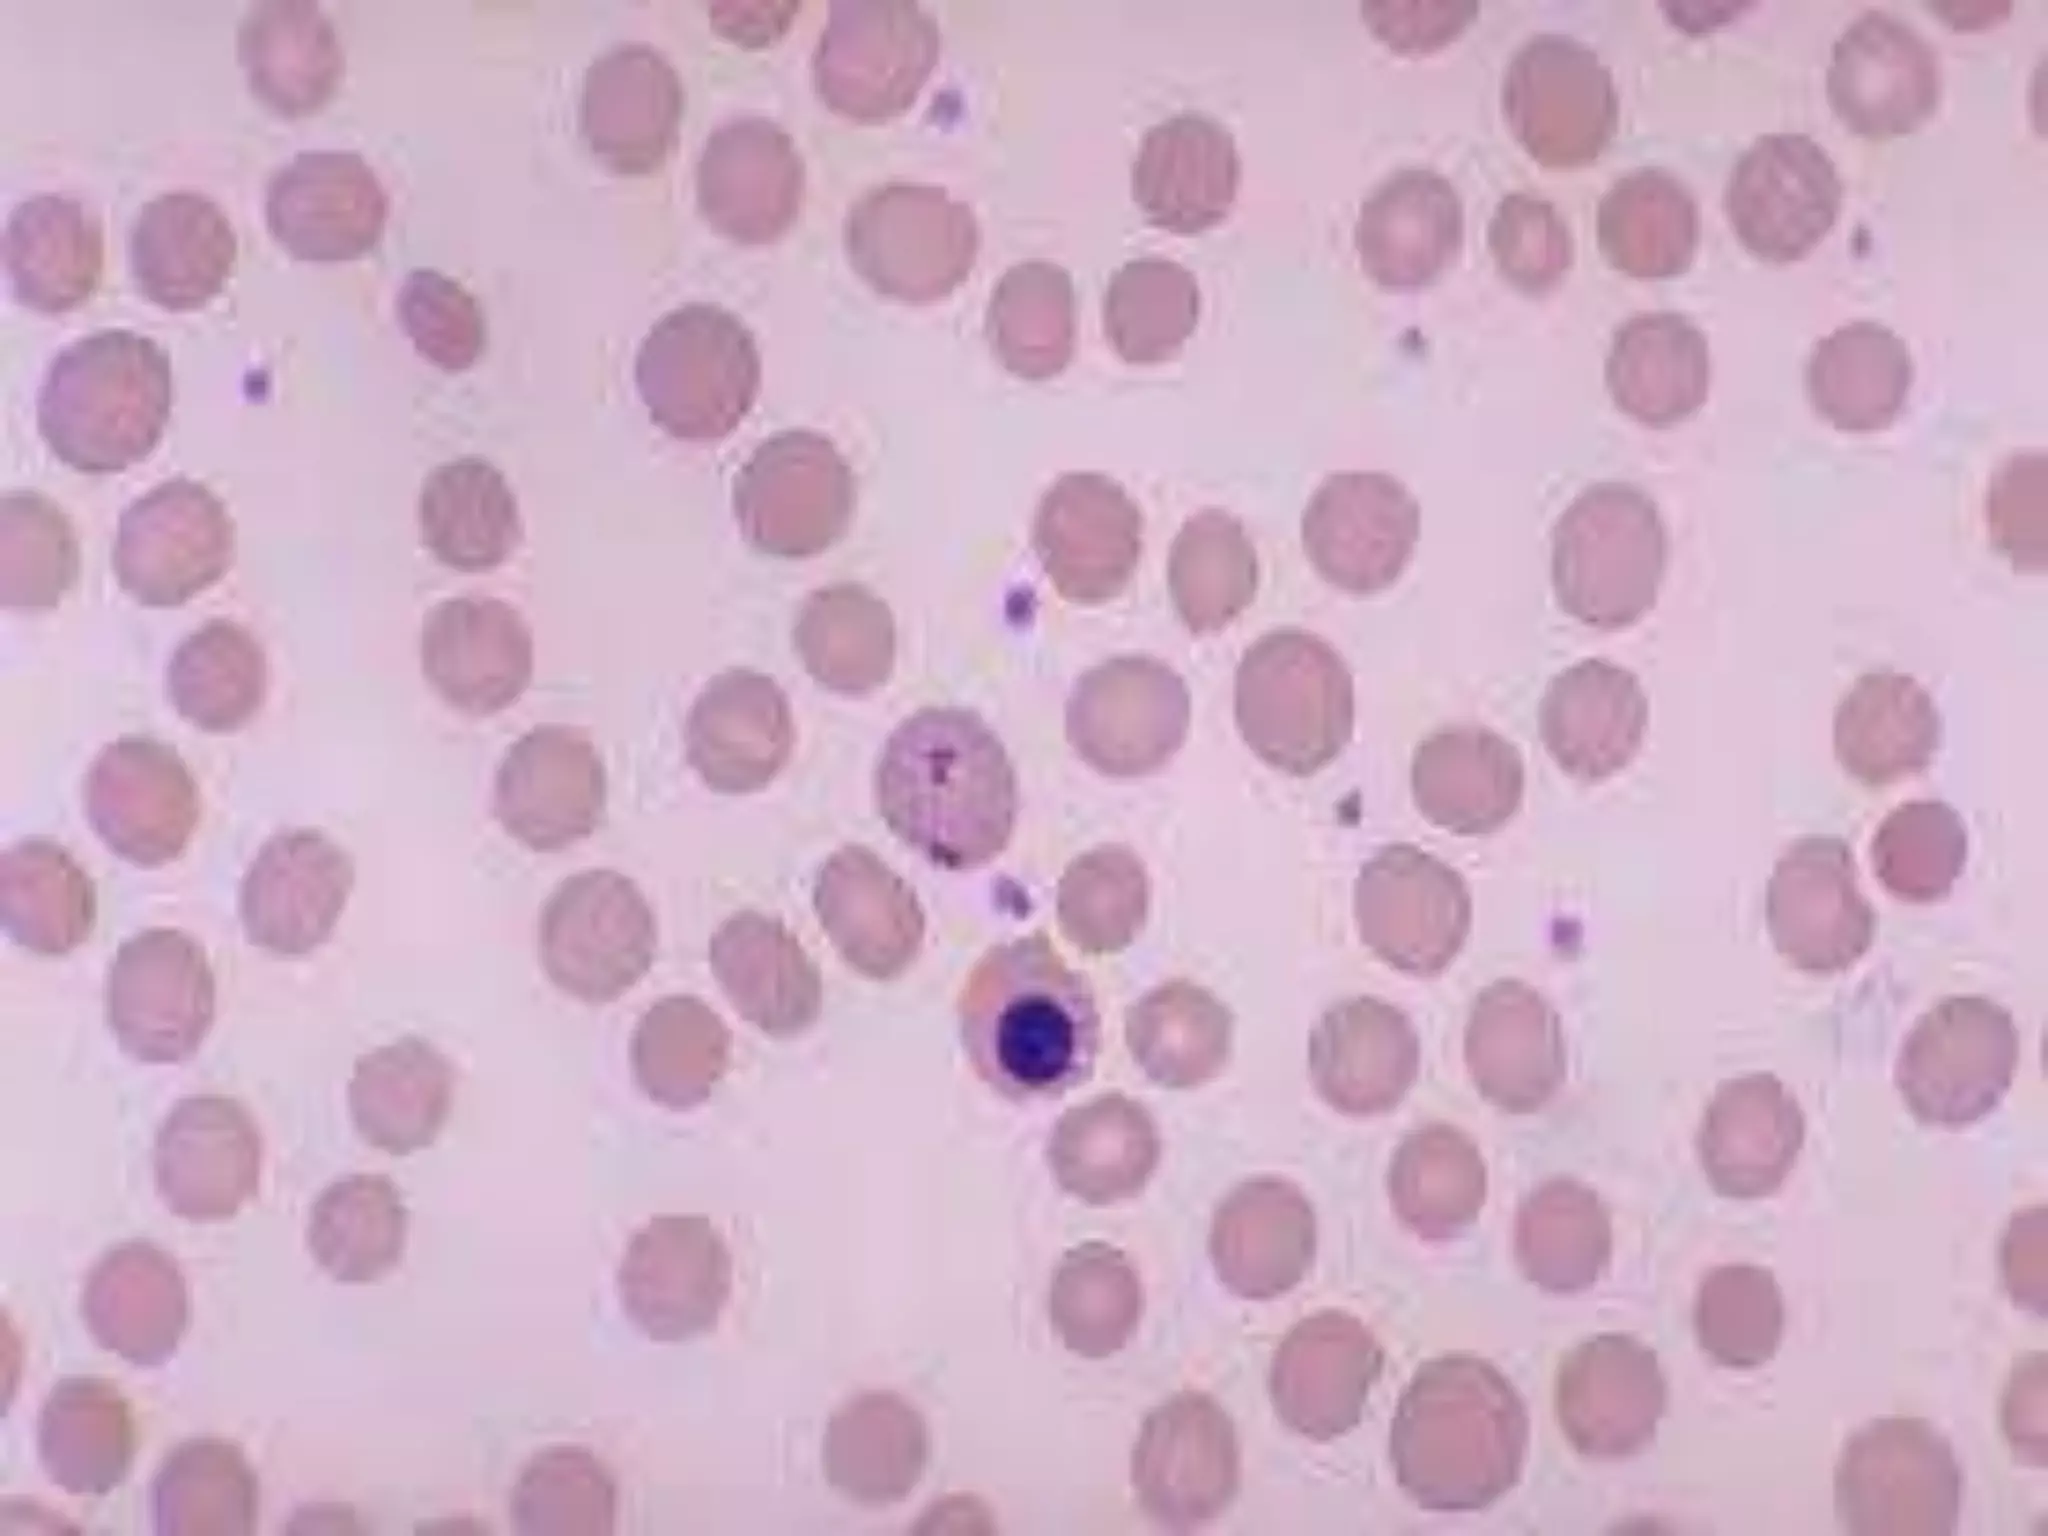

This document discusses various types of inclusion bodies that can occur within red blood cells, including Pappenheimer bodies, Howell-Jolly bodies, Heinz bodies, Cabot rings, and basophilic stippling. It provides details on the composition, appearance, causes, associated diseases, and diagnosis of each type of inclusion body. The document is presented by Group 6 to Miss Mehreen and serves to explain the different inclusion bodies that can be found in red blood cell analysis.